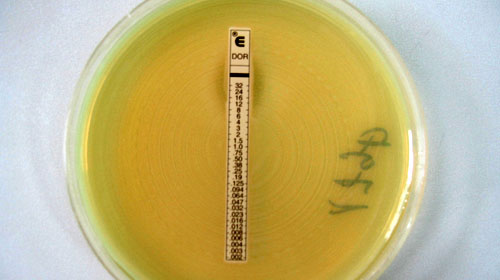

Vi khuẩn “siêu kháng thuốc” có gì đặc biệt?
Trong tự nhiên, nhiều loại kháng sinh do các loài vi khuẩn và nấm tạo ra. Kháng sinh được phân loại theo các cách khác nhau như dựa vào cấu tạo hóa học, dựa vào cơ chế tác động, dựa vào phổ tác dụng đối với vi khuẩn…Trước sự tấn công của vi khuẩn, loài người cũng đã thành công trong việc tìm ra vũ khí chống lại chúng. Antibiotic (tiếng Hy Lạp) cấu tạo từ "anti" có nghĩa là "đối lại" và "biotic" có nghĩa là "sống, cuộc sống". Antibiotic có thể được coi là những chất ngay ở nồng độ thấp đã có khả năng ức chế hoặc tiêu diệt vi khuẩn một cách đặc hiệu bằng cách gây rối loạn phản ứng sinh học ở tầm phân tử. Trong tự nhiên, nhiều loại kháng sinh do các loài vi khuẩn và nấm tạo ra. Kháng sinh được phân loại theo các cách khác nhau như dựa vào cấu tạo hóa học, dựa vào cơ chế tác động, dựa vào phổ tác dụng đối với vi khuẩn… Nhờ sự ra đời của kháng sinh, mỗi năm trên thế giới có hàng chục triệu người mắc các bệnh nhiễm khuẩn đã được chữa khỏi và cứu sống. Kháng sinh được coi như một vũ khí vĩ đại trong cuộc chiến của loài người nhằm chống lại vi khuẩn và các nhiễm khuẩn do chúng gây ra.
|
Hình phóng đại của một vết thương kinh niên bằng kính hiển vi điện tử, cho thấy một bạch huyết cầu (X) với sự hiện diện của một cụm tế bào vi khuẩn (XX). Một khi vi khuẩn không di chuyển tự do, chúng kháng lại các cách điều trị bằng thuốc kháng sinh cổ điển. |
Vi khuẩn và sự kháng kháng sinh
Tuy nhiên, trong nhiều trường hợp, mặc dù dùng kháng sinh điều trị nhưng tình trạng nhiễm khuẩn vẫn không được cải thiện, vi khuẩn vẫn tồn tại và phát triển, người ta gọi đó là đề kháng kháng sinh. Có những trường hợp vi khuẩn đề kháng nhưng đó là đề kháng giả (chỉ là biểu hiện bên ngoài chứ không phải do bản chất của vi khuẩn). Ví dụ, khi vi khuẩn gây bệnh nằm trong các ổ áp xe, ổ mủ… có các tổ chức hoại tử, tổ chức viêm bao bọc khiến cho kháng sinh không thể thấm tới vị trí tổn thương được hoặc chỉ một lượng nhỏ kháng sinh có thể tới vị trí đó. Trường hợp khác có thể gặp như khi vi khuẩn ở trạng thái không phát triển, do vậy nó không chịu tác động của kháng sinh… Nhiều loại vi khuẩn đề kháng tự nhiên với một số kháng sinh (tức là vi khuẩn không chịu tác dụng của một số kháng sinh nào đó do có những tính chất về mặt cấu trúc hay sinh lý đặc biệt khiến kháng sinh đó không thể phát huy tác dụng với vi khuẩn). Một số trường hợp đề kháng tự nhiên. Nhiều loại vi khuẩn có khả năng đề kháng kháng sinh thông qua các thay đổi về mặt di truyền (đột biến, nhận được gen qui định sự đề kháng…) người ta gọi là đề kháng thu được. Các gen kháng kháng sinh có thể lan truyền từ vi khuẩn này sang vi khuẩn khác. Các gen kháng kháng sinh tạo cho vi khuẩn đề kháng bằng nhiều cách: làm giảm tính thấm của tế bào vi khuẩn ngăn cản kháng sinh thấm vào trong tế bào hay làm rối loạn hoặc ngăn cản việc vận chuyển kháng sinh vào trong tế bào (với một số kháng sinh như tetracyclin, oxacillin…); làm thay đổi đích tác động của kháng sinh làm cho kháng sinh không bám được vào các cấu trúc của vi khuẩn và do vậy, kháng sinh không phát huy được tác dụng (streptocmycin, erythromycin…); vi khuẩn tạo ra các enzym (các men) làm biến đổi hoặc phá hủy cấu trúc hóa học của kháng sinh, do vậy, kháng sinh bị mất tác dụng (như enzyme beta-lactamase làm mất tác dụng của kháng sinh nhóm beta-lactam…).
Tìm ra NDM-1
Các kháng sinh nhóm beta-lactam thường được sử dụng rộng rãi và nhiều kháng sinh có hiệu quả trong điều trị các nhiễm khuẩn nặng. Một trong những kháng sinh có tác dụng tốt nhất trong nhóm này là các carbapenem. Tuy nhiên, các kháng sinh nhóm beta-lactam chịu tác động của enzym betalactamase của vi khuẩn, trong đó các enzyme metallo-b-lactamases (MBLs) rất hay gặp ở các P. aeruginosa, hay các vi khuẩn thuộc họ vi khuẩn đường ruột (enterobacteriaceae). Mới đây, một phân nhóm mới của MBL là NDM-1 đã được xác định từ một chủng Klebsiella pneumoniae (K. pneumoniae 05-506) có nguồn gốc ở New Dehli, Ấn Độ từ một người đàn ông 59 tuổi.
Sau khi phân tích trình tự ADN của chủng K. pneumoniae 05-506, người ta thấy có một gen mới qui định việc sản xuất ra MBL và được đặt tên là blaNDM-1. Chủng K. pneumoniae 05-506 kháng lại tất cả các kháng sinh nhóm beta-lactam được thử nghiệm (ampicillin, piperacillin, cephalothin, cefoxitin, cefotaxime, cefuroxime, ceftazidime, aztreonam, cefepime, ertapenem, imipenem, meropenem) và chỉ nhạy cảm với colistin. Người ta đã xác định rõ ràng rằng chủng 05-506 này có nguồn gốc từ Ấn Độ. Còn quá ít dữ liệu đánh giá sự lan tràn của gen này. Tuy nhiên, trên thực nghiệm tại phòng thí nghiệm, người ta thấy gen này có thể lan truyền dễ dàng giữa chủng K. pneumoniae và E. coli.
Mối đe dọa của các vi khuẩn sinh NDM-1
Vi khuẩn có các gen đề kháng sẽ ít hoặc không chịu tác động của kháng sinh khi điều trị. Đặc biệt, việc điều trị một số vi khuẩn có vai trò quan trọng gây các nhiễm khuẩn ở bệnh viện, cộng đồng như viêm phổi, viêm đường tiết niệu, nhiễm khuẩn huyết… sẽ gặp rất nhiều khó khăn. Nếu vi khuẩn đề kháng với nhiều loại kháng sinh hiện có, bệnh nhân có thể bị tử vong do thất bại điều trị.
Tuy nhiên vi khuẩn thường xuyên có sự thay đổi về cấu trúc hay sinh lý để kháng lại kháng sinh. Vì vậy điều quan trọng là chúng ta phải tuân thủ nguyên tắc sử dụng kháng sinh hết sức tránh việc lạm dụng kháng sinh nhiều hạn chế khả năng kháng thuốc của vi khuẩn.
WHO cảnh báo mối nguy của vi khuẩn siêu kháng thuốc
Tổ chức Y tế Thế giới khuyến cáo các quốc gia cần có hành động kịp thời trước sự lây lan của vi khuẩn siêu kháng thuốc, bởi vì nhân loại đang đứng trước nguy cơ mất đi vũ khí hữu hiệu để đối phó với các bệnh nhiễm khuẩn.
Theo Guardian, đây là động thái mới của Tổ chức Y tế Thế giới (WHO) sau khi giáo sư Tim Walsh (Anh) cùng các đồng nghiệp tại Ấn Độ đưa ra lời cảnh báo về sự lây lan của một nhóm vi khuẩn mang một loại gene mới, được gọi là NDM 1. Những vi khuẩn này kháng lại phần lớn các loại thuốc kháng sinh hiện có, thậm chí là nhóm kháng sinh mạnh nhất.
Theo các nhà khoa học, vi khuẩn siêu kháng thuốc này đã có mặt tại nhiều nước trên thế giới như Anh, Ấn Độ, Pakistan, Mỹ, Canada, Australia, Phần Lan... Và điều họ lo ngại là chúng có khả năng lây lan ra toàn cầu.
Trước thực trạng đó, WHO cho rằng không một quốc gia nào có thể đứng ngoài mối lo ngại này. Tất cả các nước cần có biện pháp kiểm soát sự lây nhiễm và chống việc lạm dụng, sử dụng thuốc kháng sinh sai mục đích. WHO khuyến cáo mạnh mẽ các nước cần tập trung kiểm soát 4 khía cạnh, gồm: theo dõi chặt chẽ tình hình kháng thuốc, sử dụng kháng sinh hợp lý, có biện pháp ngăn chặn tình trạng lạm dụng thuốc và tuân thủ nghiêm ngặt công tác phòng chống nhiễm trùng và các biện pháp kiểm soát sự lây nhiễm (như rửa tay bằng dung dịch sát khuẩn, đặc biệt tại các cơ sở y tế). Cũng theo WHO, cần phải nghiên cứu thêm về những vi khuẩn siêu kháng thuốc này để hiểu được nó phát triển như thế nào và tìm những phương cách hữu hiệu để khống chế. Trước đó, tại Bỉ cũng đã ghi nhận ca tử vong đầu tiên do vi khuẩn siêu kháng thuốc này. Bệnh nhân bị nhiễm khuẩn khi nằm viện ở Pakistan và đã tử vong vào hồi tháng 6.
Tại Việt Nam, theo các bác sĩ cũng đã có sự xuất hiện của vi khuẩn kháng đa thuốc mang gene tương tự như NDM 1, phổ biến nhất là nhóm vi khuẩn gram âm đường ruột.
WHO chính thức cảnh báo mối nguy hiểm của siêu vi khuẩn kháng thuốc
Tổ chức Y tế Thế giới (WHO) chính thức xác nhận loại siêu vi khuẩn có khả năng kháng thuốc rất cao mà các nhà khoa học Anh mới khám phá là một vấn đề sức khỏe công cộng nghiêm trọng trên thế giới.
 |
Các khoa học gia nói họ khám phá một loại gene mới của vi trùng |
Tuần qua, các nhà khoa học Anh đã khám phá ra gien NDM-1 có khả năng kháng thuốc rất cao ngay cả đối với những loại thuốc trụ sinh mạnh nhất là Carbapenems, vốn chỉ được sử dụng khi những thứ thuốc khác đều vô hiệu. Gene này được tìm thấy trong vi khuẩn nằm trong cơ thể của 37 người trở về Anh sau khi được giải phẫu tại Ấn Độ và Pakistan.
Trong tuyên bố chính thức, WHO nói rất cần phải nghiên cứu loại “siêu vi” này để có thể hiểu được nó phát triển như thế nào và tìm những phương cách hữu hiệu để khống chế. WHO khuyên các quốc gia nên chuẩn bị các biện pháp chống nhiễm trùng để các bệnh viện có thể hạn chế các vi khuẩn này lây lan. WHO cũng khuyến cáo các chính phủ cấm bán các loại thuốc kháng sinh nếu không có toa bác sĩ. Trước đó, các nhà khoa học cảnh báo rằng loại vi trùng kháng thuốc mạnh này đã được nhận diện nơi các bệnh nhân từ Anh, Mỹ, Australia, Canada và Hà Lan. Tất cả những bệnh nhân này đã đến Ấn Độ để chữa bệnh vì chi phí ở đó rẻ hơn.
Loại gene mới NDM-1 (viết tắt của New Delhi metallo-beta-lactamase) có trong các vi trùng có khả năng kháng hầu như gần hết mọi loại thuốc trụ sinh hiện có, kể cả nhóm thuốc kháng sinh có tên là carbapenems.
Khoa học gia David Livermore, là người đã góp phần vào việc nhận diện ra loại gene này trong vi trùng, nói rằng loại vi trùng này sẽ rất khó chữa trị nếu chúng lan tràn. Loại vi trùng mang gene NDM-1 rất thường thấy tại Bangladesh, Pakistan và Ấn Độ, và còn lan tràn nhiều hơn nữa tại những cộng đồng địa phương nơi nó lây lan do nước uống bị nhiễm khuẩn.
Theo bác sỹ Krishna Banudha thuộc đại học George Washington, NDM-1 có thể gây nhiễm trùng nghiêm trọng như sưng phổi, nhiễm trùng tiết niệu, nó có thể gây chứng nhiễm trùng máu và nhiễm trùng thận. Các chuyên gia y học toàn cầu đều nói rằng việc sản xuất được các loại thuốc kháng sinh không bắt kịp với tốc độ và mức độ lan tràn của những chứng bệnh do các loại vi trùng mới này gây ra. Theo họ, sẽ phải mất nhiều năm nghiên cứu nữa rồi người ta mới có thể tìm được một loại thuốc kháng sinh mới.
Vi khuẩn siêu kháng thuốc hay siêu PR?
Trong số báo 129 ra ngày 14/8/2010, bài phỏng vấn Giám đốc Trung tâm Phòng chống và Kiểm soát dịch bệnh Hoa Kỳ (CDC) tại Việt Nam, chúng tôi đã đề cập đến khía cạnh liệu thông tin về vi khuẩn siêu kháng thuốc (NDM-1) có phải là một con bài trong chiến lược kinh doanh của các hãng dược phẩm. Để giúp bạn đọc nắm rõ hơn vấn đề này SK&ĐS xin giới thiệu thông tin đăng tải trên báo chí nước ngoài xung quanh NDM-1.
Ngay sau khi tờ Lancet Infectious Diseases công bố về loại “siêu vi khuẩn” mới lây lan sang Anh từ Ấn Độ, chính phủ Ấn Độ đã phủ nhận thông tin liên quan đến việc lây nhiễm NDM-1 từ các bệnh nhân điều trị tại các bệnh viện Ấn Độ.Ông RK Srivastav, tổng giám đốc Trung tâm Dịch vụ Y tế Ấn Độ khẳng định: “Thông tin này đã tạo ra sự hiểu lầm nguồn gốc loại vi khuẩn này là ở Ấn Độ. Tôi kịch liệt bác bỏ thông tin là các bệnh viện ở Ấn Độ là nguồn lây lan vi khuẩn và phản đối việc đặt tên vi khuẩn theo tên thủ đô của chúng tôi”. Người đại diện của Trung tâm quốc gia Kiểm soát dịch bệnh Ấn Độ nói rằng bài báo trên tờ Lancet là “không dựa trên một số liệu khoa học nào cả”. Một số khác cho rằng nghiên cứu này là không chính xác vì chỉ có một số lượng nhỏ bệnh nhân tham gia nghiên cứu. Vishali Bali, CEO của Fortis Hospital, người đã khám cho hàng nghìn bệnh nhân trên toàn thế giới đề xuất rằng các nhà khoa học cần thực hiện nghiên cứu trên quy mô địa lý lớn hơn trước khi đưa ra kết luận chính thức.
Ngay cả Karthikeyan Kumarasamy, người phụ trách nghiên cứu này tại khu vực Ấn Độ cũng phản đối kết quả của nghiên cứu và cho rằng mình không liên quan đến kết quả đó. Ông khẳng định rằng nhiều chi tiết trong nghiên cứu đã bị thêm vào. PM Bhargava, cựu giám đốc trung tâm sinh học phân tử và tế bào ở Hyperabad nói thêm “Đã có một vài chủng vi khuẩn kháng nhiều loại thuốc như thế này và thậm chí còn nguy hiểm hơn được tìm thấy ở Mỹ hay Anh, nhưng điều này chỉ trở thành vấn đề “nguy hiểm” khi chủng vi khuẩn đó có nguồn gốc từ Ấn Độ”. Rất nhiều người trong giới chức cho rằng mọi việc đang được thổi phồng quá mức.
Giới chức y tế Ấn Độ nhấn mạnh khía cạnh là báo cáo này có khuynh hướng ủng hộ các công ty dược phẩm. Có 31 nhà nghiên cứu tham gia trong dự án này, trong đó có 12 người Ấn Độ. Những người còn lại là người Anh và Pakistan. Ông Karthikeyan K Kumaraswamy, trưởng nhóm nghiên cứu, nhận tiền trợ cấp du lịch của Wyeth, và một thành viên khác là David M Livermore nhận hỗ trợ trong việc tổ chức hội thảo của nhiều hãng dược khác nhau và cũng đang nắm cổ phần của GSK. Thành viên của tổ chức Senior Janata Party, S.S. Ahluwalia nói rằng thời điểm đưa ra nghiên cứu này là rất đáng ngờ vì nó được công bố đúng vào lúc Ấn Độ đang dần hình thành một thế lực toàn cầu trong lĩnh vực du lịch chữa bệnh. Các chuyên gia y tế từ Bangalore nói rằng báo cáo của Lancet là sự thổi phồng để tiêu diệt ngành công nghiệp du lịch chữa bệnh đang tăng trưởng nhanh chóng của Ấn Độ và là một cách để các công ty dược phẩm quốc tế đưa thêm nhiều loại thuốc và kháng sinh vào thị trường Ấn Độ. Nghiên cứu của Lancet được tài trợ bởi EU và “người khổng lồ” trong lĩnh vực dược phẩm là Wellcome Trust và Wyeth. Carbapenem hiện là loại kháng sinh thế hệ mới nhất, và việc Lancet giật tít “Vi khuẩn gram âm kháng carbapenem – vấn đề nghiêm trọng đe dọa sức khỏe toàn cầu” là tiền đề cho một thế hệ kháng sinh mới chống lại loại “siêu vi khuẩn” này?
Nói về hợp chất mới chống lại “siêu vi khuẩn” kháng thuốc, kết quả của việc hợp tác giữa GSK và Wellcome Trust, ông Ted Bianco – Giám đốc chuyển giao công nghệ của Wellcome Trust – đã tuyên bố “đây là một bước quan trọng trong cuộc chiến chống kháng thuốc kháng sinh. Bằng cách làm sáng tỏ cấu trúc mới của enzym vi khuẩn này và hiểu được cơ chế tác động của thuốc, nhóm nghiên cứu đã mở ra hướng cho thuốc kháng kháng sinh mới, cái mà chúng ta đang thực sự cần”. Mặc dù đây mới chỉ là bước đầu, bởi vì việc nghiên cứu sản xuất ra thuốc từ hợp chất này và tiến hành thực hiện các thử nghiệm trên người còn là một vấn đề mà GSK đang gấp rút thực hiện, nhưng các con số đáng nể trong lĩnh vực thuốc kháng sinh (doanh thu hàng tỷ USD mỗi năm) làm cho người ta không thể không đặt câu hỏi về một chiến lược PR mới, mà Ấn Độ chỉ là một cái đích “hợp thời điểm”.
'Siêu vi khuẩn' kháng thuốc: quá nguy hại hay chiêu 'PR'?
Thông tin về nhóm “siêu vi khuẩn” NDM-1 có khả năng kháng nhiều loại kháng sinh xuất hiện tại Việt Nam đang khiến không ít người hoang mang. Tuy nhiên, loại “siêu vi khuẩn” này có thực sự nguy hiểm như người ta vẫn tưởng?
Không quá nguy hại?  "Siêu vi khuẩn" NDM-1 không nguy hại như người ta tưởng. Ảnh: Thefirstpost. |
Trao đổi với TTX Việt Nam, PGS. TS Nguyễn Vũ Trung, Phó Trưởng Bộ môn Vi sinh, Trường Đại học Y Hà Nội, đồng thời là Trưởng khoa Xét nghiệm, Bệnh viện Bệnh Nhiệt đới Trung ương cho biết, đến thời điểm hiện tại, Việt Nam vẫn chưa có nghiên cứu cụ thể nào chứng minh việc phát hiện thấy vi khuẩn NDM-1, loại vi khuẩn được cảnh báo là kháng lại nhiều loại kháng sinh đang dùng trong công tác điều trị.
Ông Trung cũng cho rằng, việc chuyển ngữ từ “super bug” trong tiếng Anh thành “siêu vi khuẩn” kháng thuốc đã tạo nên một sự hiểu nhầm rằng đây là một loại vi khuẩn đặc biệt nguy hại, trong khi thực tế, đây chỉ là loại vi khuẩn kháng nhiều loại kháng sinh.
Theo ông Trung, trên thực tế, vi khuẩn mang gen NDM-1 là một trong những vi khuẩn kháng thuốc thông thường, được phát hiện từ năm 2007-2008 và vẫn đang được nghiên cứu tiếp về mức độ kháng thuốc. Do vậy, vi khuẩn kháng đa thuốc NDM-1, theo ông Trung là không quá nguy hại như người ta vẫn tưởng.
Vì vậy, “người dân không nên quá hoang mang khi một số thông tin từ nước ngoài cũng như trong nước có đưa tin về “siêu vi khuẩn” kháng thuốc này”, ông Trung cho hay. Trên báo chí nước ngoài, các chuyên gia cũng đã lên tiếng cảnh báo người dân không nên quá lo lắng về loại “siêu vi khuẩn” kháng thuốc này. Tân Hoa Xã dẫn lời một chuyên gia khẳng định, NDM-1 chỉ là một loại vi khuẩn có tính cảm nhiễm chứ không phải là một bệnh truyền nhiễm như SARS hay Cúm A/H1N1 do vậy sẽ không thể tạo thành các dại dịch, không cần thiết phải quá lo lắng. Dẫn lại nguồn tin từ báo chí Mỹ, Tân Hoa Xã cho biết, hiện tại NDM-1 đã lan đến Anh, Mỹ, Canada, Australia, Hà Lan,… Tính đến nay đã có hơn 170 người xác nhận bị nhiễm loại vi khuẩn này. Tuy nhiên, báo chí Mỹ cũng khẳng định, mặc dù siêu vi khuẩn có thể kháng mạnh hầu hết các loại thuốc kháng sinh, tuy nhiên không phải là không có biện pháp gì để khống chế sự lan truyền của chúng.
“Siêu vi khuẩn” hay siêu PR?
Trong khi nhiều chuyên gia khẳng định, loại “siêu vi khuẩn” không quá nguy hiểm như người ta vẫn tưởng thì nhiều nguồn tin lại cho rằng, báo cáo về loại “siêu vi khuẩn” kháng thuốc này thực chất chỉ là một chiêu tiếp thị hay PR của các hãng dược. Ngay sau khi tờ Lancet Infectious Diseases công bố về loại “siêu vi khuẩn” mới lây lan sang Anh từ Ấn Độ, chính phủ Ấn Độ đã phủ nhận thông tin liên quan đến việc lây nhiễm NDM-1 từ các bệnh nhân điều trị tại các bệnh viện Ấn Độ. Người đại diện của Trung tâm quốc gia Kiểm soát dịch bệnh Ấn Độ nói rằng bài báo trên tờ Lancet là "không dựa trên một số liệu khoa học nào cả". Một số khác cho rằng nghiên cứu này là không chính xác vì chỉ có một số lượng nhỏ bệnh nhân tham gia nghiên cứu. Ngay cả Karthikeyan Kumarasamy, người phụ trách nghiên cứu này tại khu vực Ấn Độ cũng phản đối kết quả của nghiên cứu và cho rằng mình không liên quan đến kết quả đó. Ông khẳng định rằng nhiều chi tiết trong nghiên cứu đã bị thêm vào.
 |
Và nó có thể chỉ là một chiêu PR của các công ty dược. Ảnh: Pharmas. |
PM Bhargava, cựu giám đốc trung tâm sinh học phân tử và tế bào ở Hyperabad nói thêm: "Đã có một vài chủng vi khuẩn kháng nhiều loại thuốc như thế này và thậm chí còn nguy hiểm hơn được tìm thấy ở Mỹ hay Anh, nhưng điều này chỉ trở thành vấn đề "nguy hiểm" khi chủng vi khuẩn đó có nguồn gốc từ Ấn Độ". Nhiều người cho rằng, báo cáo mà Lancet đưa ra có khuynh hướng ủng hộ các công ty dược phẩm. Bởi vì nhiều thành viên tham gia dự án này đã nhận các khoản trợ cấp và hỗ trợ của các công ty dược phẩm. Các chuyên gia y tế từ Bangalore khẳng định báo cáo của Lancet là sự thổi phồng để tiêu diệt ngành công nghiệp du lịch chữa bệnh đang tăng trưởng nhanh chóng của Ấn Độ và là một cách để các công ty dược phẩm quốc tế đưa thêm nhiều loại thuốc và kháng sinh vào thị trường Ấn Độ.
Nghiên cứu của Lancet được tài trợ bởi EU và "người khổng lồ" trong lĩnh vực dược phẩm là Wellcome Trust và Wyeth. Trong đó, Wellcom Trust là hãng dược đang tiến hành nghiên cứu sản xuất Carbapenem, thế hệ kháng sinh mới nhất. Và bài báo của Lacet về “siêu vi khuẩn” có thể là một chiêu thức quảng cáo cho thế hệ kháng sinh mới có khả năng chống lại “siêu vi khuẩn” này.
Siêu vi khuẩn kháng thuốc đã có ở Việt Nam?
Một kết quả xét nghiệm ở Bệnh viện Bệnh nhiệt đới T.Ư vừa cho thấy bệnh phẩm của bệnh nhân này kháng toàn bộ 18/18 kháng sinh được thử kháng sinh đồ...
Cầm kết quả kháng sinh đồ của một bệnh nhân viêm phổi do nhiễm trực khuẩn mủ xanh đang điều trị tại Bệnh viện Bệnh nhiệt đới T.Ư, bà Đào Tuyết Trinh, phó trưởng khoa xét nghiệm, thông báo mẫu bệnh phẩm của bệnh nhân này kháng toàn bộ 18/18 kháng sinh được thử kháng sinh đồ, trong đó có cả carbapenem là nhóm kháng sinh thế hệ mới nhất. Với những bệnh nhân này, việc chọn thuốc điều trị khá khó khăn.
 |
Cán bộ phòng xét nghiệm BV Bệnh nhiệt đới T.Ư làm việc trên máy định danh vi khuẩn Ảnh: Lan Anh |
Tuy chưa có nghiên cứu giải mã trình tự gen của tất cả vi khuẩn kháng thuốc đã phát hiện, xem loại vi khuẩn kháng thuốc ở VN có gen NDM-1 tương tự ở Ấn Độ, Pakistan, nhưng nghiên cứu ở VN cho thấy đã có những vi khuẩn kháng đa thuốc, trong đó có cả kháng sinh thế hệ mới như ở Ấn Độ.
Vi khuẩn siêu kháng thuốc
Theo PGS.TS Phạm Văn Ca, trong nghiên cứu thực hiện tại Bệnh viện Bệnh nhiệt đới T.Ư năm 2008-2009, 4% vi khuẩn klebsiella pneumoniae gây viêm phổi ở trẻ em và người già kháng kháng sinh meropenem, 55% sinh ra men ESBL. Các chủng A.Baumanii gây bệnh cơ hội ở bệnh nhân đặt ống sonde, phải thở máy, tỉ lệ kháng kháng sinh IMP tăng từ 60% lên 70%, kháng kháng sinh meropenem tăng từ 60% lên 75%. Với trực khuẩn mủ xanh, ông Ca cho hay nghiên cứu năm 2008-2009 cho thấy tỉ lệ kháng kháng sinh IMP tăng từ 35% lên 38%, kháng kháng sinh meropenem tăng từ 35,5% lên 37%.
Theo PGS.TS Phạm Văn Ca, phó trưởng khoa xét nghiệm Bệnh viện Bệnh nhiệt đới T.Ư, vi khuẩn kháng thuốc đã phát hiện tại VN từ những năm 1990. Nghiên cứu thực hiện năm 2001 trên nhiều bệnh viện toàn quốc, trong 208 chủng trực khuẩn mủ xanh được kiểm tra đã có 10,1% kháng IMP, tức carbapenem thế hệ 1. Tại Bệnh viện Bạch Mai, nghiên cứu năm 1996-1997 trên 96 chủng vi khuẩn kháng thuốc, 100% kháng ba kháng sinh trở lên, 52,9% kháng sáu kháng sinh trở lên, trong đó có cả IMP. “Tỉ lệ vi khuẩn kháng thuốc tăng lên rất nhanh. Trong nghiên cứu mới thực hiện tại Bệnh viện Bệnh nhiệt đới T.Ư năm 2008-2009, 5% vi khuẩn e.coli gây bệnh đường ruột kháng carbapenem thế hệ 1; 1% kháng kháng sinh thế hệ mới meropenem; khoảng 50% vi khuẩn được nghiên cứu sinh ra ESBL là men phá hủy tất cả kháng sinh nhóm cefalosporin như penicilin, cefalosporin, aztreo nam” - ông Ca cho biết.
Tại khu vực định tên vi khuẩn, bà Đào Tuyết Trinh cho hay dù kháng sinh nhóm carbapenem thế hệ mới nhất mới được đưa vào sử dụng 2-3 năm nay, nhưng tỉ lệ mẫu bệnh phẩm còn nhạy cảm cũng chỉ trên 90%, rất nhiều trường hợp bệnh nhân kháng 18-20 loại kháng sinh được dùng thử kháng sinh đồ. “Nếu không có biện pháp sử dụng kháng sinh hợp lý, sẽ rất khó khăn cho điều trị do nhiều vi khuẩn kháng thuốc mang gen plasmid phát triển rất nhanh. Nghiên cứu một kháng sinh mới mất hàng chục năm, nhưng vi khuẩn kháng thuốc xuất hiện hằng ngày” - bà Trinh nhận xét.
|
Vi khuẩn kháng thuốc nhóm carbapenem ở bệnh nhân điều trị tại BV Bệnh nhiệt đới T.Ư - hình tư liệu do bệnh viện cung cấp |
Do lạm dụng kháng sinh
Có nhiều nguyên nhân dẫn đến tình trạng vi khuẩn siêu kháng thuốc xuất hiện, nhưng giới y khoa đặc biệt chú ý tình trạng lạm dụng kháng sinh ở VN. PGS Ca nhấn mạnh ở VN, người dân có thể mua bất kỳ kháng sinh nào họ muốn mà không cần đơn của bác sĩ. “Uống kháng sinh không đủ liều, sử dụng thái quá, cảm cúm cũng uống kháng sinh, sử dụng thuốc không đúng bệnh. Tại bệnh viện, một số bác sĩ dùng phác đồ điều trị bao vây, chỉ định ít nhất hai kháng sinh/đơn thuốc, thậm chí có trường hợp bác sĩ ở tuyến dưới chỉ định hai kháng sinh diệt khuẩn, một kháng sinh kiềm khuẩn, sai nguyên tắc kết hợp” - PGS Ca nhận xét.
Bên cạnh đó là tình trạng sử dụng kháng sinh khá bừa bãi trong chăn nuôi cũng khiến một số thực phẩm từ động vật còn tồn dư kháng sinh, ảnh hưởng đến mức độ nhạy cảm với kháng sinh ở người. Theo PGS Ca, tùy vùng miền, nhưng người dân vùng núi, hải đảo vẫn còn nhạy cảm với nhiều loại kháng sinh, còn dân cư thành thị, từng sử dụng nhiều thuốc, tỉ lệ kháng thuốc cao hơn. Vì thế rất nên làm kháng sinh đồ cho bệnh nhân để chọn ra loại thuốc hiệu quả nhất cho họ. Một chuyên gia khác về xét nghiệm lại cho rằng “sức ép” từ các trình dược viên và cả bệnh nhân muốn dùng thuốc thế hệ mới nhất, bất kể cơ địa của mình còn nhạy cảm với kháng sinh thế hệ thấp hơn cũng là nguyên nhân làm gia tăng tình trạng kháng kháng sinh đang rất đáng lo ngại hiện nay.
Theo bà Trinh, với những bệnh nhân kháng 18-20 kháng sinh khi làm kháng sinh đồ rất khó chọn thuốc để điều trị. Các bác sĩ điều trị đành sử dụng phương án kết hợp hoặc tăng liều “kháng sinh trung gian”, tức còn có tác dụng phần nào với vi khuẩn gây bệnh. Ở những bệnh nhân này thời gian điều trị sẽ kéo dài hơn, chưa kể trong trường hợp bệnh nhân có thêm bệnh nền như đái tháo đường, tim mạch, lại nhiễm thêm vi khuẩn kháng thuốc thì rất nguy hiểm đến tính mạng.
Nhiều năm nay y khoa đã cảnh báo mức độ nguy hiểm của tình trạng người VN rất thích tự mua thuốc điều trị, bỏ qua khâu khám bệnh. Nhưng bệnh viện quá tải khiến bệnh nhân ngại đi bệnh viện, sức ép của hãng dược và kiểu điều trị “bao vây” của y khoa cũng góp phần gia tăng hiện tượng kháng kháng sinh.
Bộ Y tế cũng đã ban hành quy chế kê đơn và danh mục thuốc phải kê đơn, nhưng thực hiện trên thực tế xem ra rất khó vì tính sẵn có của hiệu thuốc tư nhân, sự thiếu thốn cả về cơ chế và lực lượng thanh tra. Nhưng sự xuất hiện của những vi khuẩn siêu kháng thuốc có thể là lời cảnh báo nghiêm khắc, không chỉ cho bệnh nhân mà cho cả bác sĩ.
Siêu vi khuẩn kháng thuốc có thật đáng lo?
Mới đây, các chuyên gia y tế thế giới đã cảnh báo về một nhóm siêu vi khuẩn có khả năng kháng nhiều loại thuốc kháng sinh, kể cả nhóm thuốc kháng sinh mạnh nhất chuyên dùng cho các ca cấp cứu và nhiễm trùng nặng do các vi khuẩn đa kháng thuốc khác gây ra, là Carbapenem.
 |
Vi khuẩn kháng thuốc gây nhiều bệnh đường ruột, cần giữ vệ sinh thật sạch tránh lây lan |
Theo BBC, nghiên cứu này được các chuyên gia Đại học Cardiff (thuộc xứ Wales), Cơ quan bảo vệ sức khỏe Anh và một số trường đại học quốc tế tiến hành. Vi khuẩn được đặt tên New Delhi Maetallo beta (NDM-1), vì liên quan đến nhóm bệnh nhân bị phát hiện trước đó đã đến Ấn Độ, Pakistan chữa bệnh và quay về Anh thì có dấu hiệu nhiễm bệnh. Đến thời điểm này, các nhà khoa học mới chỉ định được khoảng 50 ca nhiễm siêu vi khuẩn, nhưng các nhà khoa học Anh lo ngại chúng sẽ lây lan ra toàn cầu.
Loại siêu vi khuẩn NDM-1 vừa được phát hiện là một loại vi khuẩn tiết ra men (enzym) kháng lại hầu hết các loại thuốc kháng sinh. Thật ra, từ năm ngoái tiến sĩ Timothy Walsh đã phát hiện men NDM-1 ở vi khuẩn viêm phổi Klebsiella và E.coli trong cơ thể một bệnh nhân Thụy Điển tại Ấn Độ. Có hai loại kháng sinh Tigecycle và colistin tỏ ra công hiệu những ca nhiễm E.coli thông thường, nhưng nếu E.coli có chứa men NDM-1 thì không diệt được, nguy cơ tử vong rất cao.
Các chuyên gia đang lo ngại, có khả năng men NDM-1 này có thể nhảy sang các chủng khác đã kháng với nhiều loại thuốc kháng sinh. Như vậy có thể gây ra các bệnh nhiễm khuẩn nặng, có thể lây lan nhanh từ người sang người và khả năng chữa được rất thấp. Các ca nhiễm trùng NDM-1 cũng được ghi nhận ở một số nước như Mỹ, Canada, Australia, Phần Lan… vì thế đã có những cảnh báo về vấn đề này.
Các chuyên gia thế giới cho rằng, cách duy nhất để ngăn chặn sự lan truyền của siêu vi khuẩn này là cần nhanh chóng xác định và cách ly bất cứ trường hợp nào được xác định nhiễm khuẩn tại bệnh viện. Những thông tin trên đã khiến rất nhiều người lo ngại. Do đặc tính chung của vi khuẩn là có thể lây truyền rất mạnh qua giao lưu, tiếp xúc nên nguy cơ NDM-1 lan rộng và vào Việt Nam là rất lớn.
Giới chức y tế Ấn Độ cũng đã phản ứng lại các nhà khoa học Anh, cho rằng thật không công bằng khi tuyên bố loại siêu vi khuẩn kháng thuốc có khả năng lây lan toàn cầu này có xuất xứ từ Ấn Độ. Theo họ, men tạo ra tính kháng thuốc cực mạnh của siêu vi khuẩn có mặt trong môi trường, trong đường ruột người và động vật, vì thế họ phản đối gắn tên cho men nguy hiểm này là New Delhi Metallo beta lactamase, hay NDM.
Tại Việt Nam, một số phương tiện thông tin đã đưa ý kiến của các các chuyên gia trong nước cho biết đã có một vài loại siêu vi khuẩn kháng thuốc kháng sinh đã có mặt. Một chuyên gia nói, Việt Nam chưa có nghiên cứu nào giải mã trình tự gene của tất cả các loại vi khuẩn thuốc xem có phải là NDM-1 hay không, nhưng chúng ta cũng phát hiện loại vi khuẩn kháng thuốc mang gene tương tự, chẳng hạn IMP, VIM… đều kháng thuốc họ carbapenem.
Tại các bệnh viện, vi khuẩn kháng thuốc họ Carbapenem chiếm tỷ lệ khá cao, khoảng 1% - 4% chủng vi khuẩn gây bệnh đường ruột. Với những ca nhiễm khuẩn này, các bác sĩ chữa trị bằng cách áp dụng nhiều biện pháp, chọn nhiều loại kháng sinh còn nhạy cảm, phối hợp nhiều kháng sinh, điều chỉnh liều thuốc. Tuy nhiên, chi phí điều trị như thế rất cao mà hiệu quả điều trị không đảm bảo.
Các chuyên gia cho rằng, theo quy luật chọn lọc tự nhiên, mỗi một loại kháng sinh mới đưa ra sử dụng một thời gian sẽ xuất hiện chủng vi khuẩn kháng loại kháng sinh đó. Hiện tượng lạm dụng thuốc kháng sinh, sử dụng tràn lan không theo toa bác sĩ, dùng không đúng liều là những nguyên nhân khiến tình trạng vi khuẩn kháng thuốc càng gia tăng, bản thân người nhiễm bệnh sẽ bị nguy cơ cao hơn. Vì vậy, việc sử dụng thuốc kháng sinh theo chỉ dẫn của bác sĩ và vệ sinh là đều rất cần thiết để tự bảo vệ mình.
Ca tử vong đầu tiên do 'vi khuẩn siêu kháng thuốc'
|
Ảnh: Topnews. |
Một người đàn ông Bỉ được ghi nhận là trường hợp đầu tiên chết do "vi khuẩn siêu kháng thuốc" có nguồn gốc từ Nam Á. Trong khi đó, nhiều chuyên gia khuyến cáo vi khuẩn có thể lây lan ra toàn cầu. Theo ABCnews, bệnh nhân này bị nhiễm khuẩn trong khi nằm viện ở Pakistan và đã tử vong vào hồi tháng 6, một bác sĩ từ một bệnh viện của Bỉ, nơi điều trị sau cùng cho bệnh nhân này cho biết. "Trong chuyến du lịch đến Pakistan, người đàn ông này bị tai nạn ô tô và phải nhập viện vì chấn thương ở chân. Sau đó, ông trở về Bỉ điều trị tiếp tuy nhiên, ông đã bị nhiễm loại 'vi khuẩn siêu kháng thuốc'", vị bác sĩ này cho biết.
Cũng theo người bác sĩ này, mặc dù đã được điều trị bằng colistin, một loại kháng sinh mạnh nhưng bệnh nhân không qua khỏi. Một người Bỉ khác cũng được xác định nhiễm vi khuẩn siêu kháng thuốc này sau khi nhập viện do một tai nạn giao thông ở Montenegro. Tuy nhiên, bệnh nhân này sau khi về nước đã được điều trị khỏi. Trước đó, các nhà khoa học Anh đưa ra lời cảnh báo về một nhóm vi khuẩn xuất xứ Ấn Độ tạo ra một enzyme được gọi là NDM-1, có khả năng kháng lại hầu hết các loại thuốc kháng sinh. Tuy nhiên, theo Bộ Y tế Ấn Độ thì enzyme tạo ra tính kháng thuốc cực mạnh "có mặt trong môi trường, có thể là trong đường ruột của người và động vật ở khắp mọi nơi", chứ không chỉ tại quốc gia này.
Phát hiện "siêu vi khuẩn" có thể lây lan toàn cầu
Ngày 11/8, các chuyên gia y tế Anh cho biết, 1 loại vi khuẩn có khả năng chống lại các loại kháng sinh cực mạnh được phát hiện tại một bệnh viện ở Anh. Loài "siêu vi khuẩn" này có thể sẽ lây lan ra khắp thế giới.
Loại vi khuẩn này có tên NDM-1 có thể đã lây lan sang cơ thể những bệnh nhân Anh từng đến Ấn Độ hoặc Pakistan chữa bệnh. Sau đó những người này quay trở về nước để tiếp tục điều trị nên vi khuẩn NDM-1 đã được tìm thấy ở bệnh viện của Anh. Hiện vi khuẩn NDM-1 đã được tìm thấy trên cơ thể 50 bệnh nhân tại Anh, tuy nhiên các chuyên gia lo ngại nó sẽ lây lan trên phạm vi toàn cầu. Nghiên cứu ban đầu cho thấy, NDM-1 có thể tồn tại bên trong các vi khuẩn khác như E.coli và khiến "vi khuẩn chủ thể" có khả năng kháng lại một trong những loại kháng sinh mạnh nhất là Carbapenems.
Ngoài ra, vi khuẩn NDM-1 có thể "nhảy" sang hỗ trợ các chủng vi khuẩn khác vốn đang làm đau đầu giới chuyên gia nghiên cứu thuốc kháng sinh. NDM-1 có tốc độ lây lan nhanh chóng từ người sang người và sẽ bùng phát ra khắp nơi trên thế giới. Nếu điều đó xảy ra, việc chữa trị sẽ là "không thể". Một số ca lây nhiễm NDM-1 khác cũng đã được phát hiện tại Mỹ, Canada, Australia, Hà Lan và có nguy cơ trở thành một đại dịch nghiêm trọng.